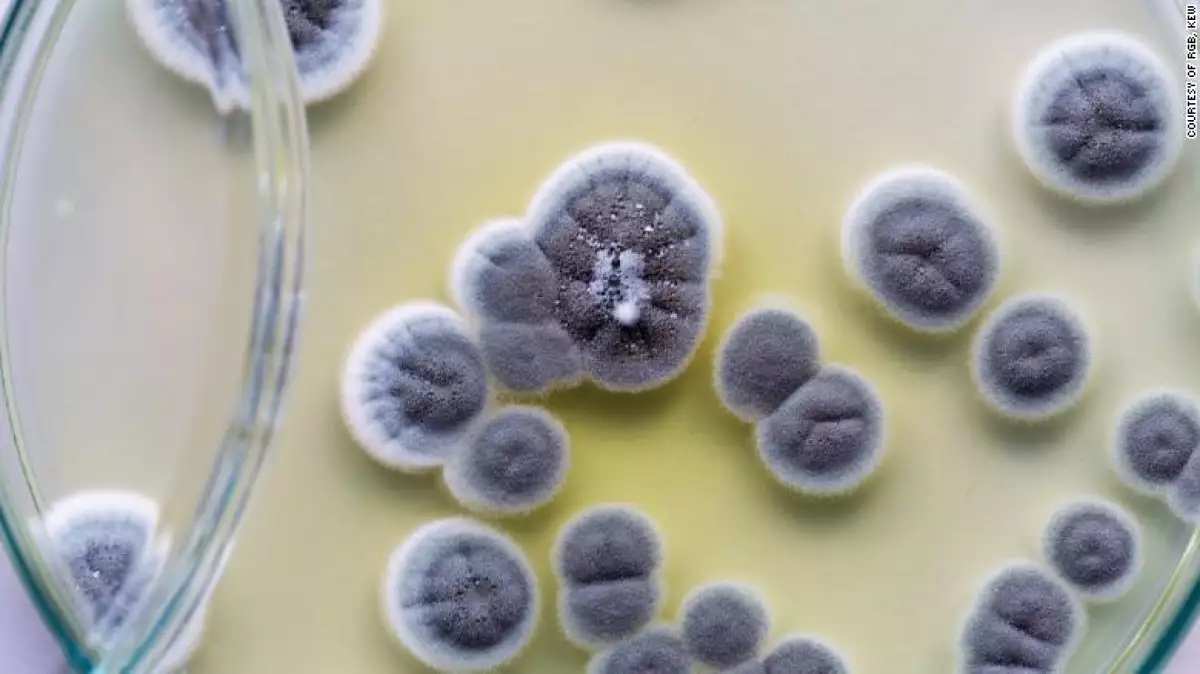

El hongo zombi que salva vidas y al planeta
(CNN) - Es una mañana soleada y Sara Landvik ha salido a explorar en el parque Hampstead Heath, uno de los espacios naturales más emblemáticos de Londres.
Examina el suelo, los árboles y sus raíces en busca de hongos, pues las largas caminatas son parte de su trabajo. Se aventura con la esperanza de descubrir nuevas especies de hongos ocultas en las profundidades de la tierra o entre los árboles.
"Queremos recolectar tantas especies de hongos como sea posible. La diversidad es realmente la palabra clave para todo lo que hacemos", explica Landvik, micóloga en la empresa de biotecnología Novozymes.
Lee: Los alimentos orgánicos pueden reducir el riesgo de padecer cáncer
Estos organismos tienen una gran cantidad de aplicaciones que pueden beneficiar a la humanidad en la producción de alimentos y alcohol, fármacos, biocombustibles, detergentes e incluso de los bloques Lego.
Su valor nutricional tampoco debe ser pasado por alto. Existen alrededor de 350 especies de hongos comestibles. Con la vitamina D, el glutatión y la ergotioneína, pueden reducir el estrés oxidativo relacionado con enfermedades como el cáncer, las cardiopatías y la demencia.
Los hongos son seres únicos, señala Landvik. "Son muy diferentes de las plantas y tan diferentes de los animales. Son su propio reino. La evolución de los hongos se ha irradiado en muchas direcciones diferentes. Son realmente increíbles".
Lee: Nanotecnología, la herramienta perfecta para combatir microorganismos
Se estima que hay hasta 3.8 millones de especies de hongos en todo el mundo, aunque solo se han descubierto alrededor de 144 mil, según el informe Estado de los Hongos en el Mundo, publicado este año y compilado por miembros del Real Jardín Botánico de Kew y otros investigadores.
Las nuevas especies se descubren peinando áreas boscosas, recolectando muestras de suelo y llevando las muestras al laboratorio para estudiarlas, dice Landvik.
Pero la verdadera habilidad no es hallarlos, sino entender cómo funcionan.

Lee: Si quieres ser vegetariano evita la trampa de la comida chatarra
En la naturaleza, los hongos no pueden moverse, por lo que compiten con otros hongos o bacterias por los recursos y, al hacerlo, producen sustancias químicas tóxicas. En algunos casos, estos químicos han sido útiles para los humanos.
Una vez que las muestras llegan al laboratorio, refiere Landvik, se cultivan dentro de una placa de Petri y se cortan en trozos, luego se colocan en un matraz con un líquido de nutrientes que contiene minerales y vitaminas y una fuente de carbono para ayudar a los hongos a crecer.
Los hongos crecen al secretar enzimas, que son capturadas por el líquido dentro del matraz, lo que permite que se estudien en profundidad.
Lee: La dieta que debes seguir para combatir el cambio climático
Miles de hongos son estudiados antes de que los investigadores se topen con uno que podría tener una aplicación, dice Landvik.
Es como un "boleto de lotería", ya que cada descubrimiento podría revelar "algo que puede hacer una diferencia en el mundo", dice.
Por ejemplo, una de las colegas de Landvik encontró una enzima que se puede usar para reducir la formación de acrilamida, que se produce cuando los alimentos con almidón se cocinan o se fríen y puede ser cancerígena. Al buscar en una base de datos secuencias genéticas homólogas, encontró secuencias de asparaginasa, también el nombre de la enzima, y pronto vio que muchos hongos contienen esta enzima. Uno de ellos se convirtió en Acrylaway, una solución que reduce la formación de acrilamida en productos alimenticios procesados a altas temperaturas que, de acuerdo con la compañía, puede reducir la formación de acrilamida hasta en un 95%.
Lee: Frutas y vegetales que pueden intoxicarte
Más famoso es el descubrimiento de la penicilina en 1928, cuando Alexander Fleming estaba clasificando sus placas de Petri después de un día festivo y vio que una mancha de moho había crecido con una zona clara alrededor. Era una cepa del hongo Penicillium notatum.
La búsqueda de enzimas útiles noventa años después todavía se basa en la casualidad.
Tom Prescott, un líder de investigación en Royal Botanical Gardens, Kew, en el Reino Unido, también señala las muchas aplicaciones útiles de los hongos.
Lee: El café y el cacao se resisten a ser cosa del pasado
‘Titiritero malvado’
Tom Prescott, jefe de investigación en Real Jardín Botánico de Kew, en el Reino Unido, también señala las muchas aplicaciones útiles de los hongos.
"En términos generales, los tres grandes temas son quizás los medicamentos, la biotecnología y, en el sentido más amplio... los hongos son realmente un buen alimento", explicó en el fungarium de Kew, una gran sala llena de filas de cajones que albergan 1.25 millones de especímenes de hongos de todo el mundo, incluidos especímenes recolectados por John Ray, Charles Darwin y Alexander von Humboldt.
Cada año se descubren nuevos hongos, dice Prescott a CNN. "Tenemos de todo, desde hongos que se pueden ver a simple vista hasta hongos microscópicos que quizás no sabías que estaban allí, pero los detectamos utilizando el ADN".
Lee: Investigadores usan baba de rana para combatir la gripe
Algunos ejemplos famosos de aplicaciones médicas son el medicamento para reducir el colesterol lovastatin, producido por el hongo Aspergillus terreus, o una vacuna contra la hepatitis B que se hace con levadura.
El fármaco fingolimod, usado para tratar la esclerosis múltiple, proviene de un llamativo hongo "zombi", Isaria sinclairii, que invade un insecto, se apodera de él y finalmente actúa como un "titiritero malvado" que controla el cuerpo y el comportamiento de su huésped para que ejecuten tareas que son ventajosas para el hongo, dijo Prescott, sosteniendo una muestra del hongo en acción.

Mientras tanto, el insecto se mantiene vivo, "por lo que es realmente espantoso", dice. "Es crucial que el hongo no mate al insecto al principio, sino que lo mantenga vivo, por eso produce un químico inmunosupresor". Esta sustancia química es la mioricina, que también suprime el sistema inmunológico humano.
Lee: Tecnología, ¿herramienta contra el desperdicio de alimentos?
"Sorprendentemente, mucha bioquímica fundamental e incluso inmunología es compartida incluso entre insectos y humanos", explica.
Los hongos también son útiles para convertir un producto químico en otro, como en la producción de tabletas de vitamina B.
Ha habido una competencia entre químicos humanos y hongos sobre cuál es mejor para producir estas píldoras, y los hongos se convirtieron en una opción más rentable, comenta Prescott.
Lee: Cofepris libera permisos para alimentos, bebidas y medicinas a base de cannabis
Salvar el medio ambiente
Aproximadamente la mitad de todas las enzimas utilizadas comercialmente se derivan de hongos, señalan Shauna M. McKelvey y Richard A. Murphy en el libro Fungi: Biology and Applications. El libro cita como ejemplo las enzimas proteasas y amilasas, utilizadas en preparaciones detergentes, como la aplicación industrial más importante de las enzimas.
El uso de enzimas en detergentes data de 1988. La lipasa, derivada del hongo Thermomyces lanuginosus, es eficaz para eliminar las manchas de grasa de la ropa.
La mayoría de los detergentes contienen varias enzimas, como proteasas, amilasas, celulasas y lipasas, para mejorar la efectividad y permitir el lavado a temperaturas más bajas.
Lee: Un hombre aumentó su esperanza de vida con este método
Los hongos también se usan para mantener la ropa fresca.

Los hongos son degradadores naturales de material de desecho, explica Prescott. En los bosques, descomponen el material de las hojas produciendo enzimas llamadas celulasas. "Sucede que si agregas celulasa a los polvos para lavar, mordisquea los diminutos hilos de algodón de las telas de algodón, y da la apariencia de que el algodón parece más nuevo de lo que realmente es".
En septiembre pasado se descubrió en Pakistán el hongo Aspergillus tubingensis. Un equipo de cien científicos informó que podía descomponer plásticos como el poliéster poliuretano, que a menudo se usa en el aislamiento de los refrigeradores, posiblemente en semanas en lugar de años, lo que podría convertirlo en un actor clave en la lucha contra el problema mundial de los desechos plásticos.
Lee: Barilla desafía a Nutella lanzando una crema de chocolate
Prescott cree que el objetivo final sería crear materiales similares a los plásticos a partir de hongos, que luego se pueden descomponer. No está claro si eso sea posible, pero "es lo que lo hace realmente emocionante", agrega.
Hongos en la agricultura
Otra forma de reducir la contaminación es agregar enzimas al pienso animal, para ayudar a los animales a descomponer nutrientes como los fosfatos, que los agricultores agregan para mejorar la salud y el crecimiento óseo de los animales.
Una enzima fúngica, la fitasa, descompone estos químicos difíciles y es especialmente útil para algunas moléculas que contienen fosfato que los animales no pueden digerir. Cuando se excretan, los fosfatos pueden ingresar en los cursos de agua, donde causan el crecimiento de bacterias. Esto también consume oxígeno en el agua, dañando el ecosistema del medio ambiente acuático, dice Prescott.
Lee: ¿Son reales los beneficios del jugo de apio?
Landvik explica que la adición de fitasa para liberar fosfatos de los piensos y ayudar a los animales a absorber este nutriente esencial también reduce los costos para los agricultores y la contaminación ambiental.
En su opinión, las enzimas fúngicas son la clave para hacer que varias industrias sean más sostenibles al reemplazar algunos pasos industriales.
"Y si tienes un paso mecánico o químico en la industria que puede ser reemplazado por una enzima que puede hacer lo mismo, tendrá menos impacto en el medio ambiente".